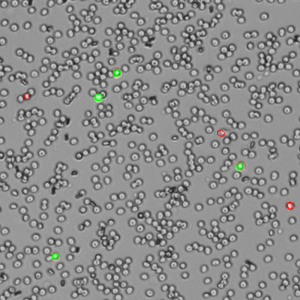
AO/PI Whole Blood Count

Trypan Blue Cell Counts
Trypan Blue works well to determine the viability of cell samples which have minimal debris. The dye is excluded from entering cells unless the membrane is damaged. The assay stains dead cells a distinctive blue color, while live cells remain transparent. The Trypan Blue apps on CellDrop Cell Counters counts live and dead cells, calculate cell concentration and report viability. The software identifies live cells as objects with a bright white center surrounded by a sharp dark ring. Stained cells are identified as an object which is dark in contrast to the background.
Trypan Blue is best suited for samples without debris, such as tissue culture cells trypsinized from a plate or flask. With debris present, identifying which objects are live cells and which are debris is challenging and subjective. Viability and counts of these samples are often overestimated when debris is counted as a cell and included in the count and viability calculation.
AO/PI Cell Counts
AO is a cell membrane-permeable nucleic acid-binding fluorophore. The dye stains the nuclei of all cells in a sample. PI is a nucleic acid-binding dye that cannot permeate live cells but is suitable for staining dead, nucleated cells.
The DeNovix AO/PI Assay is a combination of the two dyes and is optimized for accurate counting and viability assessment of nucleated cells. The AO/PI apps included on CellDrop FL Cell Counters uses images from the brightfield, green fluorescence, and red fluorescence channels. All live, nucleated cells fluoresce green due to AO. Dead, nucleated cells are stained with both AO and PI and fluoresce red due to FRET quenching of the AO dye by the PI dye. Non-nucleated cells as well as cellular debris are unstained.
The AO/PI assay is excellent for analyzing nucleated cells in samples with debris present. Peripheral blood mononuclear cells (PBMCs), for example, are difficult to quantify using brightfield techniques such as Trypan Blue assay due to the high background of non-nucleated red blood cells that are not differentiated by the dye. Conversely, measuring these samples using AO/PI is easy and accurate. Within these complex samples, nucleated cells are easily identified by green fluorescence (live) or red fluorescence (dead) against a background of non-fluorescing cells (Figure 2).
Data Comparison for AO/PI and Trypan
Cultured Cell Sample
Chinese hamster ovary (CHO) cells were chosen as a representative model for cell samples with no debris present. CHO cells were harvested from confluent culture and centrifuged at 1000 RPM for 10 minutes. The pellet was resuspended in DMEM with 10% FBS. Initial cell density was checked with a CellDrop Cell Counter.
PBMC Sample
Mouse PBMCs were isolated from whole blood with Ficoll-Paque™ (GE Healthcare cat #17-1440-02) as a representative model of cell samples with debris present. The harvested cells were centrifuged at 1500 RPM for 15 minutes to wash the sample of remaining Ficoll solution, and resuspended in PBS. Initial cell density of nucleated cells was checked with the AO/PI assay on a CellDrop FL.
Data Summary
The initial cell density of each cell sample determined by the methods above was used as a stock to prepare 3 serial dilutions with target total cell concentrations of 1.5 x 106, 1.0 x 106 and 5.0 x 105 cells/mL, with dilutions labels high, medium, and low, respectively. Each dilution was counted on a CellDrop FL five times. Figures 3 and 4 shows the results of comparing counts of CHO cells and PBMCs with Trypan Blue and AO/PI.
Summary
Automated counting and viability determination of cell samples using the CellDrop FLi removes subjectivity from the process, speeds up the workflow and enables customizable reporting and data archiving. Labs can adopt standardized methodologies that are robust against user-to-user errors and improve accuracy and reproducibility of cell counting.
Brightfield measurements using Trypan Blue are excellent for rapid reporting of cell count and viability of cell samples with minimal debris. However, the dye is subject to limitations in the ability to distinguish cells from background or debris. Dual fluorescence measurements using AO/PI enable the specific identification of live and dead cells in the presence of large numbers of non-nucleated cells and cellular debris, removing the subjectivity associated with colorimetric dyes. AO/PI is the recommended method for these common sample types:
12-DEC-2024